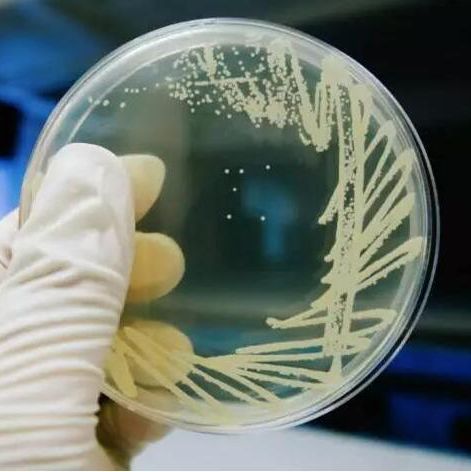
产品封面图

万千商家帮你免费找货
0 人在求购买到急需产品
- 详细信息
- 文献和实验
- 技术资料
- 库存:
55
- 英文名:
详见说明书
- 保质期:
6个月
- 供应商:
上海一研
- 保存条件:
4℃
- 规格:
100ml|500ml
(1)固体培养基。是在培养基中加入凝固剂,有琼脂、明胶、硅胶等。固体培养基常用于微生物分离、鉴定、计数和菌种保存等方面。
用于微生物分离,鉴定,计数。如图,微生物分离成菌落、菌苔。图中为大肠杆菌菌落,是用涂布平板法得到。
用于分离微生物的固体培养基
用于分离微生物的固体培养基
(2)半固体培养基。产品仅限于科研是在液体培养基中加入少量凝固剂而呈半固体状态。可用于观察细菌的运动、鉴定菌种和测定噬菌体的效价等方面。
用于观察微生物运动特征。如图,左侧试管中微生物不运动,而右侧试管中微生物运动,因而两试管中现象不同
用于观察微生物运动特征的半固体培养基
用于观察微生物运动特征的半固体培养基
(3)液体培养基。液体培养基中不加任何凝固剂。这种培养基的成分均匀,微生物能充分接触和利用培养基中的养料,适于作生理等研究,由于发酵率高,操作方便,也常用于发酵工业。
订购信息:
| 产品名称 | 淀粉水解培养基 |
| 英文名称 | 详见说明书 |
| 货号 | EYJ6684 |
英文名称:
产品规格:100ml|500ml
用途:
葡萄糖蛋白胨培养基又称葡萄糖蛋白胨水液体培养基,主要由牛肉膏、蛋白胨、淀粉等组成,室温下多呈胶胨状,需溶解后使用,多用于淀粉水解实验。
注意事项:
无菌溶液。室温下多呈胶胨状,需溶解后使用,多用于淀粉水解实验
储存条件:4℃,6个月
按培养基组成物质的化学成分区分
根据对培养组成物质的化学成分是否完全了解来区分,可以将培养基分为天然培养基、合成培养基和半合成培养基。
(1)天然培养基。天然培养基是指利用各种动、植物或微生物的原料,其成分难以确切知道。例如培养细菌常用的肉汤蛋白胨培养基:牛肉膏3g,蛋白胨5g,水1000mL。
用做这种培养基的主要原料有:牛肉膏、麦芽汁、蛋白胨、酵母膏、玉米粉、麸皮、各种饼粉、马铃薯、牛奶、血清等。用这些物质配成的培养基虽然不能确切知道它的化学成分,但一般来讲,营养是比较丰富的,微生物生长旺盛,而且来源广泛,配制方便,所以较为常用,尤其适合于配制实验室常用的培养基和大上的培养基。
这种培养基的稳定性常受厂或批号等因素的影响,另外自养微生物一般不能在其上面生长。
(2)合成培养基。合成培养基是一类化学成分和数量完全知道的培养基,它是用已知化学成分的化学药品配制而成。例如培养细菌的葡萄糖铵盐培养基:C6H12O60.2%,K2HPO40.7%,KH2PO4 0.3%,Na3C6H5O70.05%,MgSO4·7H2O0.01%,(NH4)2SO40.1%,H2O 100mL。
这类培养基化学成分精确、重复性强,但价格昂贵,而微生物又生长缓慢,所以它只适用于做一些科学研究,例如营养、代谢的研究。
(3)半合成培养基。在合成培养基中,加入某种或几种天然成分;或者在天然培养基中,加入一种或几种已知成分的化学药品即成半合成培养基。例如马铃薯蔗糖培养基等。如果在合成培养基中加入琼脂,由于琼脂中含有较多的化学成分不太清楚的杂质,故也只能算是半合成培养基。这种培养基在实践和实验室中使用最多。
FactorVII凝血因子7抗体RecombinantRatPAI1protein(Biotin)
factorV凝血因子5抗体RecombinantRatPAI1(mutated)protein(Biotin)
FactorIX凝血因子9抗体RecombinantratPAI1(mutatedI91L)protein
FactorH补体因子H抗体Anti-RAP1antibody
FactorH补体因子H抗体Anti-BrdUantibody
F-Actin纤维状肌动蛋白抗体Anti-Caspase-7antibody
FABPB脑型脂肪酸结合蛋白抗体RecombinantHumanProcalcitoninprotein
FABP7/FABP(brain)CT脑型脂肪酸结合蛋白抗体(C端)Anti-Caspase-10/CASP-10antibody
FABP6回肠脂肪酸结合蛋白抗体RecombinantratVEGFAprotein
FABP5脂肪酸结合蛋白5抗体(上皮细胞型)RecombinantHumanBMP4protein
FABP4脂肪细胞型脂肪酸结合蛋白RecombinantHumanGROalphaprotein
FAAH2脂肪酸酰水解酶2抗体RecombinantHumanGROgammaprotein
FAAH1脂肪酸酰水解酶1抗体RecombinantHumanMMP11protein
F1protein(YERSINIAPESTIS)鼠疫F1蛋白/鼠疫耶尔森氏菌荚膜抗原F1单克隆抗体RecombinantHumanEphrinB2protein
F1operonpositiveregulatoryprotein(NT)肺鼠疫耶尔森氏菌F1荚膜蛋白抗体(N端)Anti-SET/TAF-Iantibody荧光素藻红蛋白标记兔抗人、大、小鼠和果蝇CD133IgG(Tyr0)-FibrinopeptideA
抗体FibrinopeptideA(human)
肿瘤坏死因子受体超家族成员14IgGGPGG
多配体聚糖IgGGPRPPamide
多配体蛋白聚糖2/酸肝素糖蛋白1IgGGPRPPERHQS-NH2
凝血调节蛋白IgGGPRP-NH2
上皮型钙粘附分子/血管内皮钙粘蛋白IgGExperimentalAllergicEncephalitogenicPeptide(human)
抗黑色素瘤细胞粘付分子CD146IgGH-Tyr-D-Ala-Gly-OH
NK细胞抑制性受体2DL1IgGEnkephalin(2-4)
NK细胞抑制性受体2DL3IgGβ-Lipotropin(61-64)
NK细胞抑制性受体2DL4IgGYGG
抗体(D-Ala2)-Met-Enkephalinamide
NK细胞抑制性受体3DL1IgGH-Tyr-D-Ala-Gly-Phe-OH
NK细胞抑制性受体3DL1IgGPeptideF(22-34)(bovine,ovine)
NK细胞抑制性受体2DS4IgGMet-Enkephalin-KK
淀粉水解培养基 外消旋顺式盐酸舍曲林Anti-IRS1antibody[EP263Y]
外消旋坦索罗辛盐酸盐Anti-IRS1antibody[EP263Y]
外消旋酮咯酸酰基-β-D-葡萄糖苷酸(非对映异构体混合...Anti-APCantibody[EP701Y]
外消旋酮洛芬葡萄糖苷酸苄基酯Anti-APCantibody[EP701Y]
外消旋酮洛芬葡萄糖苷酸烯酯Anti-APCantibody[EP701Y]
外消旋西他列汀Anti-Bcrantibody[EP535Y]
外消旋西替利嗪N化物(非对映异构体混合物)Anti-Bcrantibody[EP535Y]
外消旋心得安β-D-葡萄糖苷酸钠盐Anti-Bcrantibody[EP535Y]
外消旋盐酸托莫西汀Anti-Sykantibody[EP573Y]
外消旋吲达帕--N-(磺酰基)酸Anti-Sykantibody[EP573Y]
外消旋吲达帕-N-磺酰基-β-D-葡萄糖苷酸Anti-Sykantibody[EP573Y]
外消旋左旋状腺素钠Anti-IRRantibody[EP327Y]
维达列汀β-D-葡萄糖苷酸Anti-IRRantibody[EP327Y]
维达列汀羧酸代谢产物Anti-IRRantibody[EP327Y]
维拉帕米基烷代磺酸盐化物Anti-MAP3K4antibody[EP551Y]端羟基外消旋聚乳酸(重均分子量28-42万)Anti-Src(phosphoY529)antibody[Y232]
端羟基外消旋聚乳酸(重均分子量3-6万)Anti-Src(phosphoY529)antibody[Y232]
端羟基外消旋聚乳酸(重均分子量42-57万)Anti-TC10antibody[Y304]
端羟基外消旋聚乳酸(重均分子量57-73万)Anti-TC10antibody[Y304]
端羟基外消旋聚乳酸(重均分子量6-9.5万)Anti-TC10antibody[Y304]
端羟基外消旋聚乳酸(重均分子量73-109万)Anti-ERK2antibody[E460]
端羟基外消旋聚乳酸(重均分子量9.5-16万)Anti-ERK2antibody[E460]
端羟基右旋聚乳酸(重均分子量0.3-1.5万)Anti-ERK2antibody[E460]
端羟基右旋聚乳酸(重均分子量1.5-3万)Anti-SHP2antibody[Y478]
端羟基右旋聚乳酸(重均分子量102-137万)Anti-SHP2antibody[Y478]
端羟基右旋聚乳酸(重均分子量137-170万)Anti-SHP2antibody[Y478]
端羟基右旋聚乳酸(重均分子量17-26万)Anti-Paxillinantibody[Y113]
端羟基右旋聚乳酸(重均分子量170-206万)Anti-Paxillinantibody[Y113]
端羟基右旋聚乳酸(重均分子量206-288万)Anti-Paxillinantibody[Y113]
端羟基右旋聚乳酸(重均分子量26-36万)Anti-ProgesteroneReceptorantibody[YR85]
培养基的保存时需注意:
淀粉水解培养基 培养基应存放于冷暗处,建议存放于普通冰箱内。放置时间不宜超过一周,倾注的平板培养基不宜超过3天。每批培养基均必须附有该批培养基制各记录副页或明显标签。
产品仅限于科研培养基(Medium)是供微生物、植物和动物组织生长和维持用的人工配制的养料,一般都含有碳水化合物、含氮物质、无机盐(包括微量元素)以及维生素和水等。有的培养基还含有抗菌素和色素,用于单种微生物培养和鉴定。
培养基由于配制的原料不同,使用要求不同,而贮存保管方面也稍有不同。一般培养基在受热、吸潮后,易被细菌污染或分解变质,因此一般培养基必须防潮、避光、阴凉处保存。对一些需严格灭菌的培养基(如组织培养基),较长时间的贮存,必须放在2~6℃的冰箱内。由于液体培养基不易长期保管,现在均改制成粉末。
风险提示:丁香通仅作为第三方平台,为商家信息发布提供平台空间。用户咨询产品时请注意保护个人信息及财产安全,合理判断,谨慎选购商品,商家和用户对交易行为负责。对于医疗器械类产品,请先查证核实企业经营资质和医疗器械产品注册证情况。
文献和实验当今,盐雾箱厂家的发展趋势无疑就三个字:自动化。面对科技水平,功能的不断提高,智能化日趋明显,仪器独立工作的能力也进入一个新的里程。 盐雾箱厂家与控制系统未来发展的关注点应当是: 1、功能安全 近年�功能安全的重要发展是,大量经过功能安全认证的仪表推向市场。为了争取竞争中有利地位,几乎所有盐雾箱厂家制造商都会开展功能安全的研究。 2、自动化仪表与企业的信息化 自动化仪表技术包括信息采集、处理和应用。“企业信息化”实际上是企业信息的集成和整合。这是
相关专题 微生物 基础培养基是人工配制的用于培养微生物的一个混合营养制品,基础培养基中含有维持微生物正常生长的营养物质,此培养基的PH值一般为7.2-7.6。某些特殊的微生物需要的PH可能偏酸或偏碱性。 培养基是根据微生物 生长繁殖时对营养物质的需要而配制的营养制品,含有营养物质及适宜的酸碱度,经灭菌后使用。 常用的培养基按用途分为:基础培养基、营养培养基、鉴别培养基、选择培养基及厌氧培养基。按物理
单层敞开式摇瓶机厂家报价? 产品说明: JY-25-54单层敞开式摇床是同类产品中技术较先进和质量完善可靠的产品,造型美观大方,数显测速,转速可任意设定,操作简便,实为生物工程、医药、卫生、微生物学等行业科研和生产使用的理想仪器. 主要特征: 1、精湛的制作工艺,确保机械运转更稳定更可靠。 2、单层敞开式摇床机芯采用优质铸铁和NSK进口轴承使机械更坚固耐用。 3、交流感应长寿命电机、款、宽调速、恒力矩、无碳刷、免保养。 4、独特的电机过热,温度失控自动断电
技术资料暂无技术资料 索取技术资料